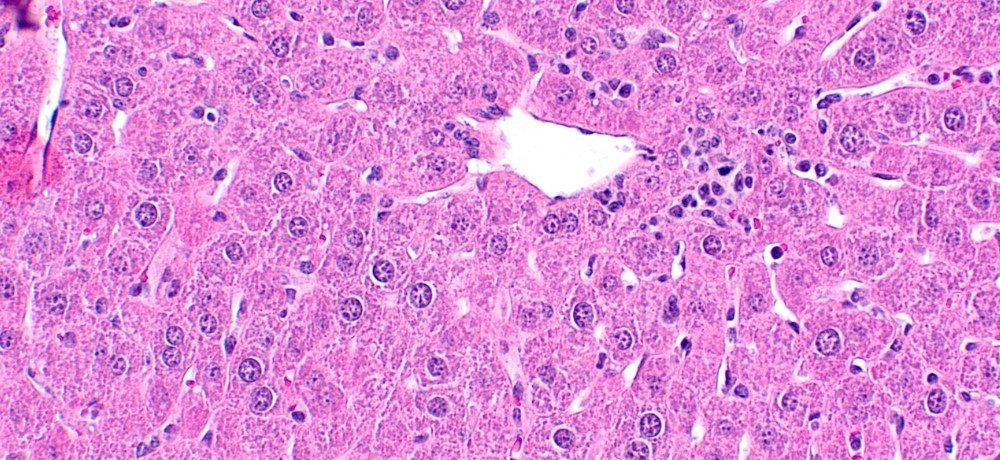

Investigating the roles of the JAK-STAT signaling pathway in hematopoiesis and hematological malignancies
Our research is focused on understanding the roles of the JAK-STAT signaling pathway, in particular the role of the transcription factor STAT5B, in processes that shape normal hematopoiesis as well as mechanisms that contribute to the pathogenesis of hematopoietic cancers. Further details on our current research projects can be found below.
Molecular mechanisms, pre-clinical models and novel targets in T-cell cancers
T-cell leukemias/lymphomas (TCLs) are a group of rare hematological malignancies of mostly incurable prospects due to limited efficient/targeted therapies and a lack of faithful pre-clinical models to test new treatment strategies. It is increasingly evident that hyperactivation of the JAK-STAT signaling pathway plays a role in TCL pathogenesis. Notably, a hotspot gain-of-function mutation in STAT5B, N642H, is frequently found in various TCL subtypes, particularly in aggressive γδ TCL entities such as hepatosplenic T cell lymphoma (HSTCL). This oncogenic mutation is associated with more aggressive disease, therapy resistance and worse prognosis.

We are developing γδ TCL models harboring this oncogenic STAT5B mutation in order to study molecular mechanisms driving disease pathogenesis and tumor microenvironment cross-talk, and to identify and test new therapeutic targets for these diseases. We use CRISPR/Cas9 functional dependency screening and (single-cell) OMICS technologies to facilitate our molecular studies. We are also establishing TCL cell lines and pre-clinical mouse models that recapitulate features of the human disease setting, which we utilize together with patient-derived TCL samples. Ultimately, from both our mechanistic and pre-clinical studies, we aim to define new targetable nodes in T-cell cancer and identify novel therapeutic strategies that could be translated to the clinics.
Mechanisms governing sex biases in hematopoiesis
Sex-specific differences in cell numbers and functions exist across many tissues, including the hematopoietic compartment, contributing to sex biases in various physiological/pathological contexts, such as blood cell homeostasis, immune responses, cancer incidence/mortality, and outcomes of hematopoietic stem cell (HSC) transplantation. However, the molecular mechanisms of these sex biases remain poorly understood. We aim to uncover and better understand mechanisms driving sex biases in the HSC compartment and in cells of the immune system. We employ in vivo models, ex vivo single-cell assays, transplantation assays and OMICS technologies to decipher novel pathways driving sex biases and how they intersect with regulation by sex hormone signaling. This work has the potential to break new ground in understanding sex biases in hematopoiesis and the immune system, relevant for various health and disease contexts.
Prognostic markers for predicting disease burden and prognosis in MPN
Polycythemia vera (PV), a subtype of myeloproliferative neoplasm (MPN), is a blood disease characterized by an increase in the levels of red blood cells, as well as white blood cells and platelets. 95% of PV patients harbor the activating JAK2V617F mutation, heavily implicating the JAK-STAT pathway in this disease. Thromboembolic events (blood clots) are the major cause of morbidity and mortality in MPN patients, however the molecular mechanisms determining increased risk or incidence of thrombosis in patients remains incompletely understood, and is a currently unmet clinical need. We are therefore using cell lines and mouse models to explore molecular variances in order to define new potential prognostic markers that can be used to stratify patients at higher risk of thrombosis and worse prognosis.

Biography
Heidi Neubauer undertook her doctoral studies in 2012 in biochemistry at the University of Adelaide, Australia, under the supervision of Prof. Stuart Pitson. Her PhD work, based at the Centre for Cancer Biology in Adelaide, focused on identifying mechanisms of cellular transformation and novel functions of oncogenic proteins. After graduating, Dr. Neubauer chose to further develop her expertise in biochemistry and cancer biology by joining the laboratory of Prof. Richard Moriggl in 2017 as a postdoctoral fellow at the University of Veterinary Medicine, Vienna. Here, her research explored oncogenic mechanisms of the JAK-STAT core cancer pathway, particularly in mature T cell leukemia/lymphoma and myeloproliferative neoplasms. In 2023, Dr. Neubauer was appointed as Assistant Professor of Molecular and Cell Biology in Biomedicine in the Unit for Medical Biochemistry at the University of Veterinary Medicine Vienna.
Dr. Neubauer is the recipient of several awards including a Vetmeduni Vienna ‘Young Scientist of the Year’ Award (2019, 2021 and 2022), the Royal Adelaide Hospital Medical Staff Society Research Prize (2016), and the ‘David Walsh Prize’ of the Australia and New Zealand Society for Cell and Developmental Biology (2015).
Top Publications
Aung MMK, Schönefeldt S, Pfalz-Kraupp S, Wais T, Suske T…..Grebien F, Bekiaris V, Herling M, Moriggl R and Neubauer HA (2025) A STAT5B-driven mouse model of hepatosplenic γδ T cell lymphoma reveals therapeutic efficacy of JAK inhibitors. bioRxiv; doi: 10.1101/2025.10.24.684333.
Fortelny N*, Farlik M*, Fife V, Gorki A-D, Lassnig C, Maurer B, Meissl K…..Neubauer HA, Moriggl R, Knapp S, Sexl V, Strobl B, Decker T†, Müller M† and Christoph Bock† (2024) JAK-STAT signaling maintains homeostasis in T cells and macrophages. Nature Immunology, 25(5): 847-859; doi: 10.1038/s41590-024-01804-1.
Schönefeldt S, Wais T, Herling M, Mustjoki S, Bekiaris V, Moriggl R and Neubauer HA (2021) The diverse roles of γδ T cells in cancer: from rapid immunity to aggressive lymphoma. Cancers, 13: 6212; doi: 10.3390/cancers13246212.
de Araujo ED*, Erdogan F*, Neubauer HA*, Meneksedag-Erol D et al (2019) Structural and functional consequences of the STAT5BN642H driver mutation. Nature Communications, 10(1): 2517; doi: 10.1038/s41467-019-10422-7. *co-first authors
Neubauer HA, Tea MN, Zebol JR, Gliddon BL et al (2019) Cytoplasmic dynein regulates the subcellular localization of sphingosine kinase 2 to elicit tumor-suppressive functions in glioblastoma. Oncogene, 38(8): 1151-1165; doi: 10.1038/s41388-018-0504-9.
Funding
European Hematology Association (EHA) Advanced Research Grant
Heidi Neubauer was awarded an Advanced Research Grant from the European Hematology Association (EHA) to study molecular mechanisms underlying sex-specific differences in hematopoiesis, which could contribute to sex biases in various physiological/pathological contexts, such as blood cell homeostasis, immune responses and cancer incidence/mortality. This 3-year grant (2025-2028) will support the use of in vivo models, ex vivo single-cell assays, transplantation assays and OMICS technologies to decipher novel pathways driving sex biases and how they intersect with regulation by sex hormone signaling.

EP PerMed EU-Funded Project
The project “Interrogation of the immune-microenvironment of T-cell malignancies” (ImmuneT-ME) aims to develop a comprehensive understanding of the immune microenvironment of various T-cell leukemia/lymphoma entities in order to facilitate the development of new prognostic biomarkers and personalized therapies.
The consortium consists of nine interdisciplinary members including cancer biologists, clinical hematologists, bioinformaticians and patient organizations, capitalizing on unique resources such as clinical registry linked sample repositories, in-silico machine learning tools, new high-fidelity mouse models and patient advocacy networks.
For more details, please visit the EP PerMed project database.

Special Research Programme (SFB) “Monarchies and Hierarchies in Shaping Chromatin Landscapes”
A network of internationally competitive research teams in Vienna join forces to deploy next-generation sequencing and proteome technologies based on strong bioinformatics competence. The mission is to discover how the JAK-STAT pathway drives the complex reorganization of the genome when cells undergo pathophysiological changes.
The research network includes subprojects led by Mathias Müller and Birgit Strobl (Vetmeduni Vienna), Heidi Neubauer and Richard Moriggl (Vetmeduni Vienna), Veronika Sexl and Barbara Maurer (Vetmeduni Vienna), Thomas Decker and Matthias Farlik (Max Perutz Labs, University of Vienna), Sylvia Knapp (Medical University of Vienna) and Christoph Bock and Thomas Krausgruber (CeMM).
For more details, please visit the JAK-STAT SFB website.

FWF Principal Investigator Project: The Role of STAT5B in Thrombosis and Myeloproliferative Neoplasms
Heidi Neubauer was awarded funding from the Austrian Science Fund (FWF) to support her research on Myeloproliferative Neoplasms and thrombosis. This four year project (2022-2026) will explore the role of the protein STAT5B in MPN disease mechanisms, where STAT5B could represent a novel prognostic marker and help explain patient phenotypes in these diseases.